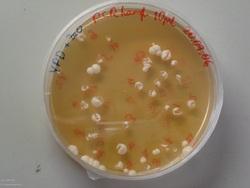
Imagen portada

Actividad complementaria
Actividad complementaria
Imagen
Imagen
Imagen
Imagen
Actividad complementaria